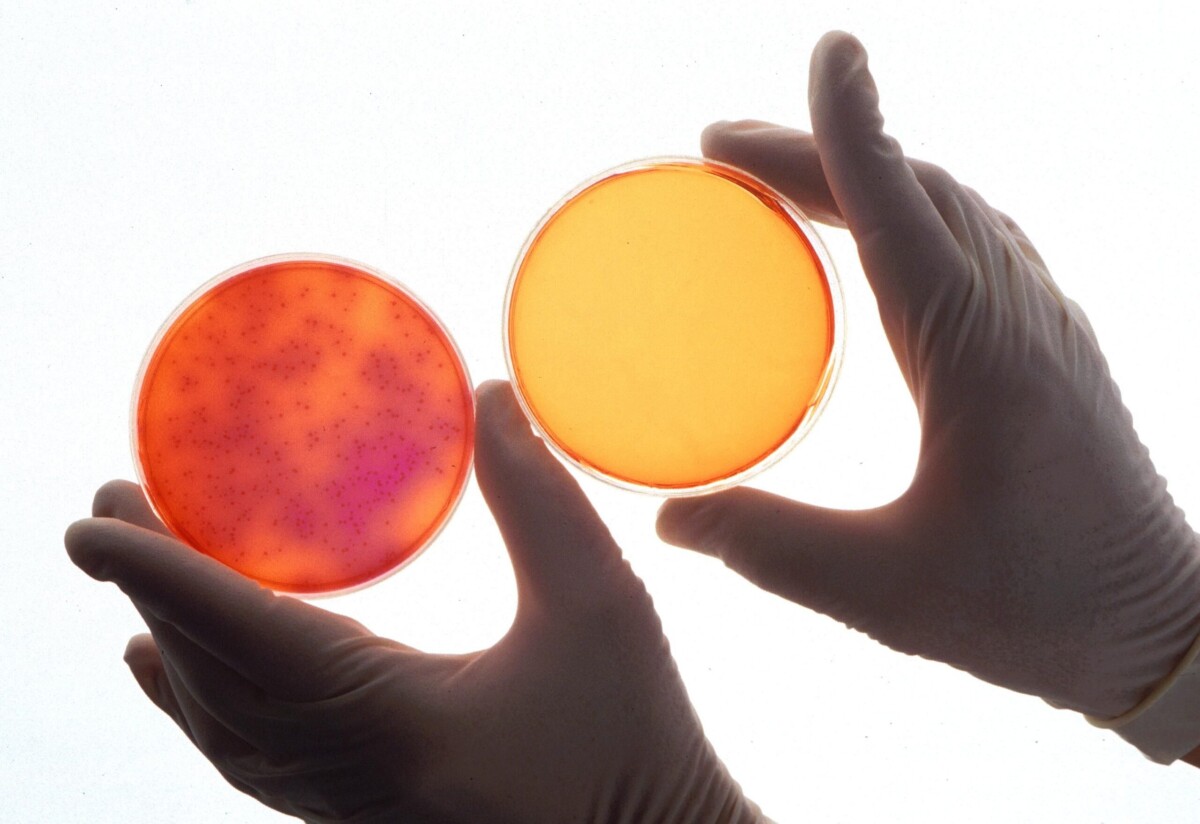

Placa Petri De Plástico 100 X 15 Mm, Estéril
Placa Petri De Plástico 100 X 15 Mm, Estéril
S/ 18.00
Las Placas Petri están fabricadas en vidrio resistente al calor, la placa y la tapa vienen libres de burbujas. Las tapas se adaptan perfectamente al cuerpo permitiendo un manejo fácil. Base extremadamente plana garantiza una dispersión uniforme de los medios y un crecimiento celular uniforme
Las Placas Petri están fabricadas en vidrio resistente al calor, la placa y la tapa vienen libres de burbujas. Las tapas se adaptan perfectamente al cuerpo permitiendo un manejo fácil. Base extremadamente plana garantiza una dispersión uniforme de los medios y un crecimiento celular uniforme. El cuerpo pulido y los bordes de la tapa permiten un uso seguro reduciendo el riesgo de rotura.
Compartir producto:
Envío Gratis
Pedidos mayores a 99 soles
Compra segura
Por cada compra
Description
Las Placas Petri están fabricadas en vidrio resistente al calor, la placa y la tapa vienen libres de burbujas. Las tapas se adaptan perfectamente al cuerpo permitiendo un manejo fácil. Base extremadamente plana garantiza una dispersión uniforme de los medios y un crecimiento celular uniforme. El cuerpo pulido y los bordes de la tapa permiten un uso seguro reduciendo el riesgo de rotura.